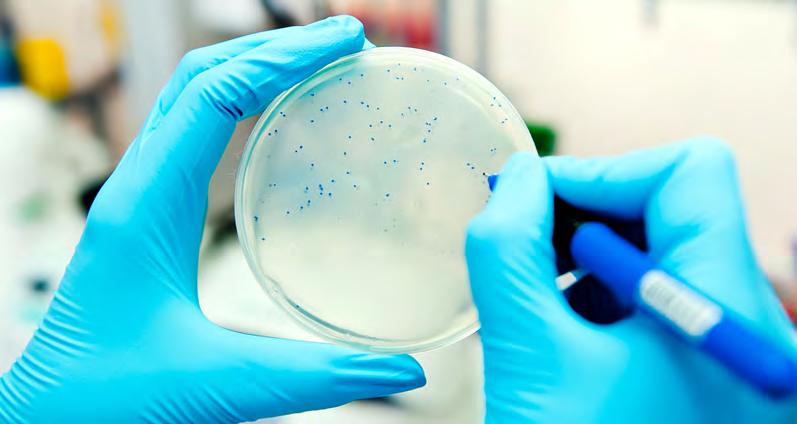

Antibacteriële conditionering van textiele luchtverdeelslangen
Nieuwe antibacteriële behandeling
Klimaat installaties moeten regelmatig onderhouden worden in verband met de hygiëne en prestaties van het systeem. Ook textiele luchtverdeelslangen moeten met regelmaat gereinigd worden. Het is daarom belangrijk dat ze eenvoudig kunnen worden gedemonteerd en worden gewassen bij een gespecialiseerd reinigingsbedrijf.
Met het oog op het verbeteren van de hygiëne heeft KE Fibertec, samen met Christeyns (reinigings-producent voor de professionele schoonmaak industrie), een antibacteriële behandeling ontwikkeld. Zowel nieuwe als bestaande luchtverdeelslangen kunnen hiermee behandeld worden.
Voordelen van de antibacteriële behandeling:
• Voorkomt microbiële groei op textiele kanalen
• Getest volgens EN ISO 20645:2004 en EN ISO 20743:2013
• Geen zilverionen of andere gevaarlijke chemicaliën
• Milieuvriendelijk
In de voedingsindustrie is een hoog niveau van hygiëne van groot belang. Textiele luchtverdeelslangen zijn voor deze industrie zeer geschikt vanwege een efficiënte luchtverdeling en het lage risico op condensatie. Daarnaast laat het materiaal geen groei van micro-organismen toe vanwege het nietorganische polyestermateriaal (bij een relatieve vochtigheid onder 85% RV.)
In omgevingen met een hogere relatieve vochtigheid (>85% RV) zoals bijvoorbeeld slachthuizen, zuivelfabrieken, koelhuizen, verticale landbouw faciliteiten en broodfabrieken kunnen problemen optreden die gepaard gaan met de groei van micro-organismen en schimmels. Schimmels en microbiële besmetting kunnen leiden tot groot kwaliteitsverlies en zorgen voor vlekken in het materiaal die niet uitwasbaar zijn.

KE Fibertec heeft, samen met Christeyns (Reinigingsproducent voor de professionele schoonmaakindustrie), een antibacteriële behandeling ontwikkeld en biedt deze nieuwe optie aan om een mogelijke microbiële besmetting op de textiele luchtverdeelslangen nog verder uit te sluiten.


KE Fibertec heeft zich gespecialiseerd in het produceren van textiele luchtslang materialen met de hoogste stofopnamecapaciteit en kan daarmee de langste reinigingsintervallen bieden. De luchtverdeelslangen kunnen nu al in de fabriek de antibacteriële behandeling ondergaan.
AA Service en Onderhoud, dochteronderneming van KE Fibertec, is gespecialiseerd in het onderhoud van textiele luchtkanalen. De antibacteriële behandeling is nu opgenomen als optie in het reinigingsprogramma.
Een nieuwe antibacteriële behandeling kan bij reiniging standaard door AA Service en Onderhoud worden aangeboden.
AA Service en Onderhoud biedt een totaalpakket van advies, bezoek, drukmetingen, demontage, reiniging, vermaking/reparatie en montage van de textiele luchtkanalen. Zo houden wij de kwaliteit van de textiele luchtkanalen hoog en de klant tevreden.
